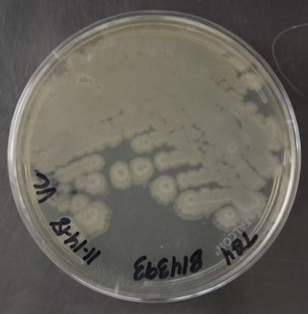
bacillus amyloliquefaciens fungicida

Qué es bacillus amyloliquefaciens
Bacillus amyloliquefaciens es una bacteria gram positiva, formadora de endosporas, ampliamente reconocida por su aplicación en la agricultura como bioestimulante y agente de biocontrol. Se encuentra naturalmente en suelos y tejidos vegetales, donde actúa tanto en la rizosfera como en el interior de las plantas. Bacillus amyloliquefaciens habitat: principalmente suelos agrícolas, rizosfera y tejidos internos de la planta (endófito), donde puede persistir y ejercer biocontrol.
Es uno de los bacillus más potentes en agro cuando la cepa está bien elegida, porque combina colonización (rizosfera/endófito) con un arsenal de lipopeptidos (surfactina, iturinas, fengicinas) y señales que pueden activar defensas y mejorar vigor. Eso sí: también es un grupo con historia taxonómica liosa y con rendimiento muy “depende”.
La presencia de esta bacteria en productos agrícolas ha crecido gracias a su eficacia demostrada en el control de hongos y al impulso hacia prácticas más sostenibles. Su rol en la promoción del crecimiento vegetal también lo posiciona como un pilar en la bioestimulación.
Para qué sirve bacillus amyloliquefaciens
El principal uso de bacillus amyloliquefaciens es el control biológico de hongos fitopatógenos mediante la producción de compuestos antifúngicos. Pero su función va más allá: también estimula el crecimiento vegetal, mejora la tolerancia al estrés y promueve la salud del suelo.
Biocontrol “de verdad” (especialmente antifúngico) por lipopeptidos: en un endófito de Hedera helix detectaron secreción de surfactin, iturin, bacillomycin y fengycin, junto a antibiosis frente a patógenos.
Bioestimulación / PGPR: esa misma cepa endófita mostraba IAA, enzimas hidrolíticas y solubilización de fosfato, además de promover crecimiento.
Inducción de resistencia (no solo “mata patógenos”): en tomate, una cepa aislada de su rizosfera se asocia a mejora de crecimiento y a reducción de la fecundidad de Tuta absoluta vía respuestas defensivas.
Distribución funcional de su actividad en el agroecosistema
Según modelos funcionales actuales, bacillus amyloliquefaciens distribuye sus funciones de forma equilibrada en distintos frentes del ecosistema agrícola. Se estima que:

- Un 29 % de su energía metabólica se destina a la colonización vegetal.
- Un 21 % a su actividad de biocontrol directo (antibiosis, competencia, micoparasitismo).
- Un 19 % a la comunicación y señalización vegetal (incluyendo compuestos volátiles).
- Un 17 % al reciclaje y disponibilidad de nutrientes.
- Un 14 % a generar condiciones de defensa indirecta y resistencia inducida.
Esta distribución refleja un perfil biológico muy completo, donde el microorganismo no solo protege, sino que interactúa, alimenta y fortalece a la planta en múltiples niveles.
Cómo actúa bacillus amyloliquefaciens
Bacillus amyloliquefaciens actúa a través de múltiples mecanismos:
- Colonización de raíces y tejidos internos de las plantas (endofitismo).
- Producción de lipopeptidos antifúngicos como surfactina, iturina, fengicina y bacillomicina.
- Inducción de resistencia sistémica en la planta huésped.
- Producción de fitohormonas como el ácido indolacético (IAA).
- Solubilización de fósforo y producción de enzimas hidrolíticas.
Puede colonizar de forma sistémica: en Hedera helix reportan colonización de hojas, pecíolos y semillas (esto te sirve para hablar de “microbios que se vuelven parte del cuerpo de la planta”).
En maíz se ha descrito reclutamiento/afinidad con exudados radiculares en contextos de interacción con patógenos (idea potente: “la planta llama a su microbiología cuando hay amenaza”).
Bacillus amyloliquefaciens como fungicida

La aplicación de bacillus amyloliquefaciens como fungicida se basa en su capacidad de antibiosis directa. Los lipopeptidos que produce alteran la membrana de los hongos y detienen su crecimiento.
Esta acción se ha probado contra una amplia gama de patógenos incluyendo Fusarium, Botrytis, Alternaria y Colletotrichum. Lo más destacable es que estos efectos no dependen solo del contacto directo, sino también de su capacidad para activar defensas en la planta.
Lista detallada de hongos y bacterias inhibidos
Bacillus amyloliquefaciens no solo combate hongos comunes, sino que ha demostrado eficacia frente a un amplio rango de fitopatógenos. Se ha documentado su acción inhibitoria contra hongos como Podosphaera spp., Colletotrichum spp., Alternaria spp., Fusarium spp., Botrytis cinerea y Sclerotinia spp.
En cuanto a bacterias, se ha probado su capacidad para controlar organismos altamente destructivos como Ralstonia solanacearum (marchitez bacteriana) y Pectobacterium carotovorum (pudrición blanda), lo que lo convierte en un aliado clave para sistemas productivos afectados por enfermedades complejas.
Procesos bioquímicos precisos
Más allá de su acción antibiótica, bacillus amyloliquefaciens participa en procesos bioquímicos muy sofisticados. Entre ellos destaca la producción de enzimas deshidrogenasas, esenciales para el metabolismo del carbono y la liberación de nutrientes. Además, puede generar compuestos volátiles orgánicos, como 2,3-butanodiol y acetoin, que funcionan como señales químicas para activar defensas en la planta huésped.
También interviene en procesos de formación de biofilms, creando estructuras microbianas estables en la raíz que favorecen su permanencia y efecto prolongado. Esta combinación de mecanismos lo convierte en una herramienta compleja y eficaz para agricultura de precisión.
Curiosidades técnicas útiles
Uno de los aspectos menos conocidos pero más interesantes es que bacillus amyloliquefaciens puede colonizar a nivel sistémico, llegando a encontrarse en hojas, pecíolos, semillas e incluso frutos. Esta capacidad lo posiciona como un «microbio residente» dentro del sistema vegetal, más allá de la rizosfera.
Además, es uno de los pocos microorganismos agrícolas que puede cultivarse de forma casera, usando medios simples como patata cocida, agar, aloe esterilizado o extracto de levadura, lo que lo hace accesible incluso para pequeños productores o ensayos experimentales.
Bacillus amyloliquefaciens en la naturaleza
En la práctica, es habitual encontrarlo como rizosférico y/o endófito en muchas plantas. Ejemplos bien documentados:
- Hiedra inglesa (Hedera helix): endófito con colonización sistémica y efectos de crecimiento/protección.
- Maíz (Zea mays): aislamiento endofítico desde raíz en suelos alcalinos.
- Tomate (Solanum lycopersicum): cepa aislada de rizosfera de tomate, con efectos en crecimiento y defensa.
- Vid / uva (Vitis spp.): trabajos que aíslan endófitos de tejido de vid para biocontrol (p.ej., mildiu).
- Goji (Lycium barbarum): ensayos con cepas endófitas/PGPR contra pudriciones de raíz.
- Arroz (Oryza sativa): aislamientos endofíticos reportados desde semilla.
En la agricultura integrativa que practicamos, no dependemos de cepas comerciales ni de terceros. Recogemos bacillus amyloliquefaciens directamente de la propia finca, porque es esa bacteria local la que ya está adaptada al suelo, al clima y al ecosistema microbiano específico del lugar. Esto nos permite trabajar con un microorganismo que no solo es eficaz, sino que forma parte natural del equilibrio biológico del entorno agrícola.
Bacillus amyloliquefaciens cepa D747 y otras cepas destacadas
La palabra clave es “cepa”, no especie: dentro de B. amyloliquefaciens hay cepas muy buenas y otras mediocres para tu objetivo (patógeno, suelo, cultivo, clima, formulación).
Una de las más conocidas es la cepa D747, incluida en productos como Serifel (BASF). También destaca la cepa QST 713, usada en el conocido producto Serenade.
Serenade bacillus amyloliquefaciens es uno de los biofungicidas más aplicados en frutales, vid y hortícolas. Su fama proviene de su acción preventiva y su compatibilidad con otras estrategias.
Bacillus amyloliquefaciens comprar: opciones y marcas
En el mercado puedes encontrarlo bajo distintas marcas comerciales. Algunas de las más destacadas incluyen:
- Certis: incluye formulaciones con cepas específicas para biocontrol.
- Syngenta: integra esta bacteria en programas integrados de manejo de plagas.
- Bayer: comercializa soluciones como Serenade.
- Productos genéricos: formulaciones líquidas o en polvo con distintas cepas.
Es fundamental conocer la cepa y el fabricante. Algunos productos pueden estar mal etiquetados, especialmente cuando se confunde con Bacillus velezensis.
Taxonomía y etiquetado: B. amyloliquefaciens y B. velezensis son muy cercanas (mismo “operational group”), y distinguirlas no siempre es trivial; esto importa porque puede haber productos/aislamientos “mal nombrados”.
Bacillus amyloliquefaciens precio: el precio varía mucho según el formato, la concentración y la cepa. Para comparar precios, conviene revisar la concentración de unidades formadoras de colonias (UFC) y si el producto tiene certificación ecológica.
Bacillus subtilis vs bacillus amyloliquefaciens
Ambas especies son del mismo género y comparten propiedades similares. Sin embargo, bacillus amyloliquefaciens suele producir un rango más amplio de lipopeptidos, lo que le confiere mayor eficacia antifúngica.
Bacillus subtilis es más conocido en biofertilización y como probiótico, mientras que amyloliquefaciens destaca más en biocontrol.
Bacillus amyloliquefaciens pdf y recursos científicos
Existen numerosos estudios científicos publicados en revistas como MDPI, Frontiers o Springer, que validan sus funciones:
- Estudios sobre control de Alternaria tenuissima en hiedra.
- Ensayos sobre aumento de biomasa en tomate y maíz.
- Evaluación de actividad antifúngica en condiciones de campo.
- Validación molecular de genes de surfactina, iturina y fengicina.
- Análisis de colonización sistémica y efectos sobre semilla.
Estos recursos en formato pdf son una fuente valiosa para agrónomos, investigadores y técnicos agrícolas.
La cepa lo es todo
Uno de los errores más comunes al usar bacillus amyloliquefaciens es asumir que cualquier producto con ese nombre funciona igual. Pero en realidad, cada cepa es un mundo. Puedes tener dos productos con la misma especie y obtener resultados completamente diferentes.
La palabra clave es “cepa”, no especie: dentro de B. amyloliquefaciens hay cepas muy buenas y otras mediocres para tu objetivo (patógeno, suelo, cultivo, clima, formulación).
Esto se debe a que no todas las cepas producen el mismo perfil de lipopeptidos, ni tienen la misma capacidad de colonización o compatibilidad con el cultivo. Algunas son mejores como fungicidas, otras como bioestimulantes y otras… simplemente no hacen nada en ciertas condiciones.
Casos reales: cuando funciona (y cuando no)
Hay experiencias muy positivas con productos que contienen cepas bien seleccionadas y formuladas. Por ejemplo, en hiedra inglesa (Hedera helix), se ha documentado colonización sistémica con efectos reales sobre crecimiento y defensa.
Resiliencia a estrés: hay aislamientos endofíticos en maíz (de raíz) seleccionados por tolerancia a condiciones alcalinas/sódicas, con enfoque explícito en mejorar crecimiento bajo estrés.
Pero también hay experiencias frustrantes: formulaciones mal conservadas, bacterias inactivas por temperatura o pH, o cepas no adaptadas al cultivo. En algunos casos, agricultores han invertido en productos caros sin resultados visibles, simplemente porque la cepa no era adecuada para su sistema productivo.
Limitaciones reales y puntos ciegos
No todo lo que reluce es oro, y esto también aplica a los bioinsumos. Aunque bacillus amyloliquefaciens tiene mucho potencial, también tiene sus límites:
- Alta dependencia del contexto: tipo de suelo, microbiota nativa, condiciones climáticas y sistema de riego afectan directamente su eficacia.
- Sensibilidad en formulación: productos mal almacenados o expuestos a temperaturas extremas pueden perder viabilidad.
- Competencia microbiana: si ya hay muchos microorganismos en el suelo, puede no colonizar bien.
- Resultados no inmediatos: a diferencia de un químico, los efectos pueden tardar días o semanas en aparecer.
Por eso es clave acompañar el uso de bacillus con seguimiento técnico y análisis microbiológico del suelo, si es posible.
Cómo saber si el producto vale la pena
Aquí van algunas recomendaciones prácticas:
- Revisa si la etiqueta indica la cepa concreta (por ejemplo: D747, QST 713).
- Comprueba si menciona UFC por ml o por gramo (lo ideal es más de 1×10⁷ UFC/g).
- Pregunta si está registrado en el registro de fertilizantes o fitosanitarios de tu país.
- Prefiere productos con documentación científica y respaldo técnico.
Además, busca siempre productos con proveedores serios que brinden asesoramiento técnico. Una cepa buena mal aplicada es como una semilla sin riego: no sirve.
Microbiología en la planta: ¿mito o realidad?
Puede colonizar de forma sistémica: en Hedera helix reportan colonización de hojas, pecíolos y semillas (esto te sirve para hablar de “microbios que se vuelven parte del cuerpo de la planta”).
Esto abre una idea fascinante: hay microbios que pueden convertirse en parte del sistema de defensa y nutrición de la planta, como un órgano vivo más. En la práctica, esto se traduce en mayor tolerancia a estrés y mejor respuesta a enfermedades sin necesidad de aplicar constantemente.
En maíz se ha descrito reclutamiento/afinidad con exudados radiculares en contextos de interacción con patógenos (idea potente: “la planta llama a su microbiología cuando hay amenaza”).
¿Por qué algunos productos fallan?
Hay varios motivos por los cuales un producto con bacillus amyloliquefaciens puede no funcionar:
- La cepa usada no produce los metabolitos esperados (por ejemplo, no secreta fengicinas ni surfactina).
- Se aplica fuera de tiempo (por ejemplo, con alta carga de patógeno ya instalada).
- El suelo tiene pH o salinidad extremos que bloquean la acción bacteriana.
- No se hace reinoculación o mantenimiento poblacional.
- Se mezcla con productos incompatibles (fungicidas químicos, por ejemplo).
Por eso, siempre es recomendable hacer una estrategia integrada y entender bien la lógica de acción de estas bacterias.
Taxonomía confusa: ¿estoy usando bacillus amyloliquefaciens o velezensis?
Taxonomía y etiquetado: B. amyloliquefaciens y B. velezensis son muy cercanas (mismo “operational group”), y distinguirlas no siempre es trivial; esto importa porque puede haber productos/aislamientos “mal nombrados”.
Esto implica que lo que en la etiqueta aparece como bacillus amyloliquefaciens podría ser realmente una cepa de bacillus velezensis. ¿Importa esto? Sí. Porque puede tener implicaciones en su eficacia, compatibilidad legal y hasta en su perfil de seguridad.
Algunas cepas de B. velezensis son muy eficaces como fungicidas, pero otras no tanto. Si tu cultivo depende de un resultado claro, esta diferencia puede marcar el éxito o fracaso del tratamiento.
Aplicación práctica: recomendaciones finales
Para aprovechar al máximo este microorganismo, aquí van algunas prácticas recomendadas:
- Aplica en etapas tempranas del cultivo.
- Usa en conjunto con biofertilizantes compatibles.
- Mantén las condiciones de suelo adecuadas (no compactado, con humedad suficiente).
- Aplica de forma localizada si es posible (enraizamiento, goteo, fertirriego).
- Haz pruebas en una parcela pequeña antes de escalar.
Si puedes combinar bacillus amyloliquefaciens con micorrizas o consorcios bacterianos bien diseñados, el efecto suele ser mayor.
Conclusión
Bacillus amyloliquefaciens puede marcar una gran diferencia en rendimiento, sanidad vegetal y sostenibilidad. Sus propiedades antifúngicas, su capacidad de colonizar la planta, y su potencial como bioestimulante lo hacen ideal para programas sostenibles y estrategias integradas de manejo.
No se trata de reemplazar químicos, sino de construir sistemas agrícolas más inteligentes, donde las bacterias trabajen junto con la planta, no contra el ambiente.
Si quieres mejorar tus resultados o hacer una transición hacia una agricultura más sostenible, podemos ayudarte.
Si no solo buscas mejorar resultados sino el límite a la producción
Si quieres diferenciarte de verdad tener más control y menos dependencia, ¡ podemos ayudarte !
Elige uno de nuestros servicios (consultoría, asesoría, análisis y formación) para avanzar hacia una agricultura más eficiente y sostenible
y vemos qué encaja para ti